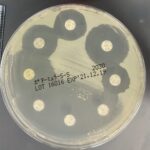
薬剤感受性試験の様子

ブログ
Blog
ブログ
Blog
大阪府吹田市・豊中市・箕面市の皆さん。こんにちは。 院長の福間です。 今回は、ちょっと聞きなれない言葉かもしれませんが「耐性菌(たいせいきん)」について書いていこうと思います。 みなさん、耐性菌って知ってい…

こんにちは。 ESSE動物病院の院長 福間です。 今回は、犬に多い膝の病気である『前十字靭帯断裂(ぜんじゅうじじんたいだんれつ)』とその治療である『TPLO』について紹介しようと思います。 &…

大阪府吹田市・豊中市・箕面市の皆さん。こんにちは。 大阪府吹田市のESSE動物病院の動物看護師 高谷です☆ 暑い夏がやってきました!外に出たら汗びっしょりですね…(-_-;) &…

こんにちは!ESSE動物病院看護師の玉城です^^ 今回のテーマは「全身麻酔」についてです! 動物病院で行われる手術と聞いて1番に思い浮かぶのが避妊手術や去勢手術ではないでしょうか?そんな避妊・去勢手術や、歯石除去なども全…